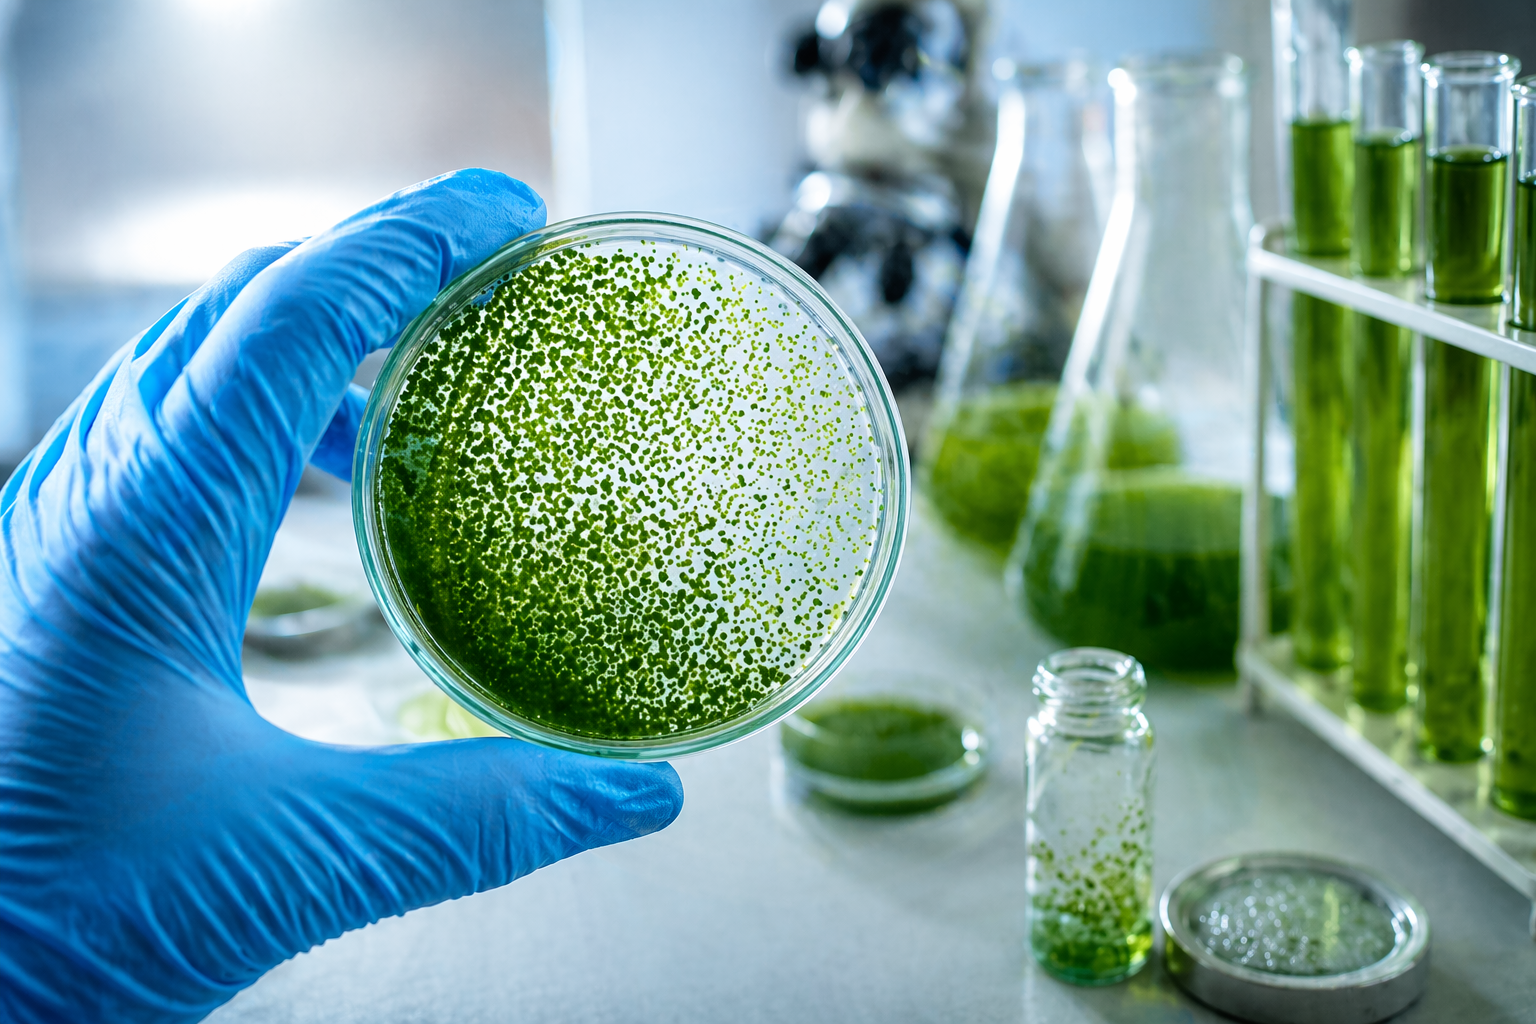

Biorrefinería de Algas: Estrategias para una Industria Sostenible
En un mundo cada vez más consciente del impacto ambiental y de la necesidad de alternativas naturales, las algas han surgido como una solución verdaderamente revolucionaria. Ya no son solo organismos que habitan en los océanos; hoy se reconocen como auténticas biofábricas, capaces de transformar la luz solar y el dióxido de carbono en una amplia variedad de productos de alto valor, que van desde alimentos y cosméticos hasta biocombustibles.
¿Qué es una biorrefinería de algas?
El concepto de biorrefinería toma como referencia a las refinerías de petróleo, pero con un enfoque sostenible. En lugar de obtener un único producto, este modelo busca el aprovechamiento integral de la biomasa, maximizando la obtención de múltiples compuestos, minimizando los residuos y optimizando el uso de energía. Se trata, en esencia, de un sistema basado en la economía circular, donde cada componente del alga es valorizado tanto desde el punto de vista económico como ambiental.
Estrategias según el tipo de alga
La industria de las algas se organiza principalmente en tres grupos, cada uno con enfoques y aplicaciones específicas:
Cianobacterias (como Spirulina)
Son microorganismos de rápido crecimiento con gran capacidad para producir compuestos de alto valor, como ficobiliproteínas (pigmentos naturales) y ácidos grasos poliinsaturados. Una estrategia clave es la extracción secuencial, donde primero se recuperan los compuestos más valiosos y, posteriormente, los residuos se transforman en biodiésel o biogás mediante procesos de fermentación.
Microalgas (como Chlorella y Dunaliella)
Destacan por su alto contenido en proteínas, lípidos y pigmentos como el betacaroteno. Una de las estrategias más prometedoras consiste en integrar su cultivo con el tratamiento de aguas residuales, aprovechando los nutrientes presentes para generar biomasa que luego puede convertirse en energía u otros productos.
Macroalgas (algas marinas)
Tradicionalmente utilizadas en la alimentación, su potencial en biorrefinería se centra en la extracción de polisacáridos como agar, alginatos y carragenanos. La biomasa residual puede reutilizarse como fertilizante de alta calidad o como fuente para la generación de energía térmica y eléctrica.
Desafíos y perspectivas futuras
A pesar de su enorme potencial, la implementación a gran escala de las biorrefinerías de algas enfrenta desafíos importantes:
- Altos costos iniciales: Las tecnologías de cultivo, cosecha y procesamiento requieren inversiones significativas.
- Complejidad técnica: Es necesaria una integración eficiente de procesos biológicos, químicos e industriales.
- Desarrollo de mercado: Garantizar la calidad, seguridad y competitividad de los productos es clave para fortalecer la confianza del consumidor.
Conclusión
La transición hacia una industria basada en algas no solo representa una oportunidad económica para el desarrollo de productos bioactivos innovadores, sino también un paso crucial hacia la sostenibilidad global. Gracias a la colaboración entre la academia y la industria, se están superando las barreras tecnológicas, acercándonos cada vez más a convertir a las algas en el eje de una nueva bioeconomía verde.